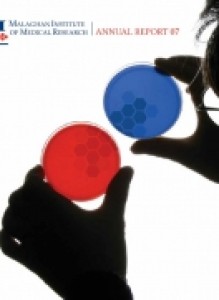

Our annual reports detail our research, governance and financial activities for the year ending 31 July.

Annual Report 2024/25
13 October 2025
Read more

Annual Report 2024
18 October 2024
Read more

Annual Report 2023
13 November 2023
Read more

Annual Report 2022
21 November 2022
Read more

Annual Report 2021
16 December 2021
Read more

Annual Report 2020
1 December 2020
Read more

Annual Report 2019
1 December 2019
Read more

Annual Report 2018
1 December 2018
Read more

Annual Report 2017
1 December 2017
Read more

Annual Report 2016
1 December 2016
Read more

Annual Report 2015
1 December 2015
Read more

Annual Report 2014
1 December 2014
Read more

2013 Annual Report
1 December 2015
Read more

Annual Report 2011-2012
1 December 2012
Read more

Annual Report 2010 - 2011
1 December 2011
Read more

Annual Report 2009-2010
1 December 2010
Read more

Annual Report 2008
1 December 2008
Read more
Annual Report 2007
1 December 2007
Read more

Annual Report 2006
1 December 2006
Read more
